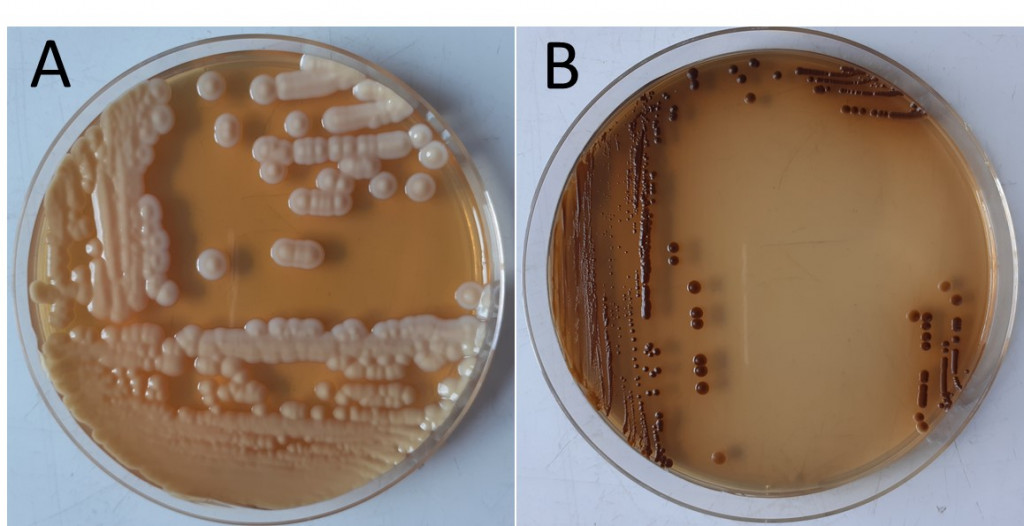
Figure 3

Septembre 2021
Les complexes d’espèces Cryptococcus neoformans et Cryptococcus gattii
REGNE : Eumycota (Fungi)
PHYLUM : Dikarya, Basidiomycota
CLASSE : Tremellomycètes
ORDRE : Tremellales
FAMILLE : Cryptococcaceae
GENRE : Cryptococcus
Le genre Cryptococcus comprend des levures rondes, encapsulées, de taille hétérogène pouvant aller de 5 µm à 7 µm de diamètre. La taille de la capsule est également variable (de 0,4 à 0,7 µm). Elle est composée de mannoprotéines et de deux polysaccharides, le glucuronoxylomannane et le galactoxylomannane. Sept espèces pathogènes pour l’homme sont aujourd’hui reconnues dans le genre Cryptococcus, réparties au sein de deux complexes d’espèces : le complexe Cryptococcus neoformans avec C. neoformans et C. deneoformans, et le complexe C. gattii qui comprend 5 espèces (C. gattii sensu stricto, C. bacillisporus, C. deuterogattii, C. tetragattii et C. decagattii). Il faut également signaler l’existence de 3 génotypes distincts pour l’espèce C. neoformans sensu stricto, et de 3 hybrides, ce qui représente un total de 12 génotypes (Figure 1).

Ces levures sont présentes dans l’environnement. Classiquement, les principales sources environnementales sont les sols contaminés par les fientes de pigeons et les arbres. Récemment, la recherche de nouveaux biotopes a permis d’isoler ces levures du sable et d’eau de rivière, mais aussi de prélèvements vétérinaires (chats, furets, etc…) et d’insectes. Par ailleurs, il a été admis pendant longtemps que les espèces du complexe gattii seraient plus fréquentes en zone tropicale et celles du complexe neoformans cosmopolites. Ceci est largement controversé aujourd’hui, l’ensemble des espèces de ces deux complexes étant aujourd’hui considérées comme cosmopolites.
Les levures du genre Cryptococcus sont responsables d’une pathologie affectant le système nerveux central, la cryptococcose. Cette mycose opportuniste est très fréquente chez les individus infectés par le VIH, mais elle est également de plus en plus souvent rapportée chez des individus immunocompétents, notamment après contamination par les membres du complexe gattii. Le nombre de cas annuels de cryptococcose a considérablement diminué depuis une dizaine d’années, il était de 278 000 en 2014, avec 180 000 décès survenus pour la majorité d’entre eux (135 000 environ) en Afrique subsaharienne où l’on rencontre une grande diversité d’espèces et de génotypes.
La contamination s’effectue par inhalation de spores, conduisant à une primo-infection pulmonaire souvent asymptomatique. La levure persiste cependant dans l’organisme sous une forme latente et se réactive à la faveur d’une immunosuppression ; elle traverse alors la barrière hémato-encéphalique au cours d’un épisode de fongémie, et pénètre dans le compartiment cérébral, engendrant alors une forme symptomatique. Les signes cliniques d’une cryptococcose ne sont pas toujours spécifiques et parmi les plus fréquents, on retrouve les céphalées, la fièvre, l’altération de l’état général et la raideur méningée. La symptomatologie peut être faible et le syndrome méningé peut être absent.
Le diagnostic de certitude est établi par la mise en évidence de la levure et des antigènes capsulaires (glucuronoxylomannanes) solubles dans le liquide cérébrospinal (LCS) principalement, mais aussi dans le liquide de lavage broncho-alvéolaire, les urines, le sang ou encore à partir d’une biopsie cutanée en cas de lésions cutanées. Le LCS est généralement clair, avec une formule à prédominance lymphocytaire, une hyperprotéinorachie et une hypoglycorachie. L’examen direct du LCS s’effectue après coloration à l’encre de Chine. La capsule forme un halo incolore autour de la levure (Figure 2). Une coloration de Gram peut aussi permettre de visualiser la levure.

Les cryptocoques présentent une croissance lente sur milieu de Sabouraud sans cycloheximide (Figure 3A). Les colonies matures sont obtenues en 3 à 5 jours à 37°C ; elles sont de couleur blanc-crème, muqueuses et brillantes. Deux milieux de culture sélectifs sont également décrits pour les levures du genre Cryptococcus : le milieu aux graines de Niger sur lequel la synthèse de mélanine est stimulée (Figure 3B) et le milieu CGB (Canavanine, glycine et bleu de bromothymol) (Figures 4A et 4B) où seules les levures du complexe gattii se développent en provoquant l’acidification du milieu par utilisation de la glycine, ce qui engendre le virage de l’indicateur coloré au bleu.

L’identification repose sur la spectrométrie de masse de type MALDI-TOF qui peut permettre l’identification précise au sein des deux complexes d’espèces. La PCR est utilisée lors d’études épidémiologiques en vue de déterminer le sérotype et le génotype des souches.
En France, le traitement de cette mycose consiste en un traitement d’induction associant l’amphotéricine B liposomale (3 mg/kg/jour) et la 5-fluorocytosine (100 mg/kg/jour) pendant deux semaines. Si l’évolution clinique et microbiologique est favorable, un traitement de consolidation est ensuite initié, à base de fluconazole (6 mg/kg/jour) pendant 8 semaines, suivi d’un traitement d’entretien à base de fluconazole (200 mg/jour) qui sera poursuivi jusqu’à ce que le taux de CD4 soit à deux reprises supérieur à 200/mm3. Des ponctions lombaires régulières sont effectuées pour objectiver la négativation des cultures à partir du LCS, mais aussi pour diminuer l’hypertension intracrânienne. De nouvelles recommandations ont été émises par l’OMS en 2018, à destination des pays du Sud en particulier, avec un traitement d’induction associant l’amphotéricine B (1 mg/kg/jour) et la 5-fluorocytosine (100 mg/kg/jour) pendant 1 semaine, puis du fluconazole (1200 mg/jour) en monothérapie pendant 1 semaine. Puis, un traitement de consolidation avec du fluconazole (800 mg/jour) est instauré pendant 8 semaines, toujours avec des ponctions lombaires évacuatrices. Néanmoins, il demeure important d’étudier la sensibilité in vitro de tout isolat de cryptocoque, des différences de sensibilité étant signalées d’une espèce à l’autre, avec par exemple une moindre sensibilité de l’espèce C. deuterogattii au fluconazole.
Pour plus d’informations, consulter :
- Hagen F, Hare Jensen R, Meis JF, Arendrup MC. Molecular epidemiology and in vitro antifungal susceptibility testing of 108 clinical Cryptococcus neoformans sensu lato and Cryptococcus gattii sensu lato isolates from Denmark. Mycoses. 2016;59(9):576–84.
- Rajasingham R, Smith RM, Park BJ, Jarvis JN, Govender NP, Chiller TM, Denning DW, Loyse A, Boulware DR. 2017. Global burden of disease of HIV-associated cryptococcal meningitis: an updated analysis. Lancet Infect Dis. 17(8):873–81.
- Chen SC, Meyer W, Sorrell TC. Cryptococcus gattii infections. Clin Microbiol Rev. 2014;27(4):980–1024.
- Bertout S, Roger F, Drakulovski P, Martin AS, Gouveia T, Kassi F, Menan H, Krasteva D, Delaporte E, Bellet V. African ST173 Cryptococcus deuterogattii strains are commonly less susceptible to fluconazole: An unclear mechanism of resistance. J Glob Antimicrob Resist. 2020;21:262–9.
- Kassi FK, Drakulovski P, Bellet V, Roger F, Chabrol A, Krasteva D, Doumbia A, Landman R, Kakou A, Reynes J, Delaporte E, Menan HEI, Bertout S. Cryptococcus genetic diversity and mixed infections in Ivorian HIV patients: A follow up study. PLoS Negl Trop Dis. 2019;13(11):e0007812.
- Guidelines for the diagnosis, prevention and management of cryptococcal disease in HIV-infected adults, adolescents and children, WHO 2018.
- Dos Santos Bentes A, Wanke B, Dos Santos Lazéra M, Freire AKL, da Silva Júnior RM, Rocha DFS, Pinheiro SB, Zelski SE, Matsuura ABJ, da Rocha LC, de Souza ES, de Souza JVB. Cryptococcus gattii VGII isolated from native forest and river in Northern Brazil. Braz J Microbiol. 2019;50(2):495–500.
- Cogliati M, D’Amicis R, Zani A, Montagna MT, Caggiano G, De Giglio O, Balbino S, De Donno A, Serio F, Susever S, Ergin C, Velegraki A, Ellabib MS, Nardoni S, Macci C, Oliveri S, Trovato L, Dipineto L, Rickerts V, McCormick-Smith I, Akcaglar S, Tore O, Mlinaric-Missoni E, Bertout S, Mallié M, Martins Mda L, Vencà AC, Vieira ML, Sampaio AC, Pereira C, Criseo G, Romeo O, Ranque S, Al-Yasiri MH, Kaya M, Cerikcioglu N, Marchese A, Vezzulli L, Ilkit M, Desnos-Ollivier M, Pasquale V, Korem M, Polacheck I, Scopa A, Meyer W, Ferreira-Paim K, Hagen F, Theelen B, Boekhout T, Lockhart SR, Tintelnot K, Tortorano AM, Dromer F, Varma A, Kwon-Chung KJ, Inácio J, Alonso B, Colom MF. Environmental distribution of Cryptococcus neoformans and C. gattii around the Mediterranean basin. FEMS Yeast Res. 2016;16(4):fow045.
Virginie Bellet et Sébastien Bertout
(UMI 233 IRD-UM INSERM U1175 TransVIHMI, « Infections mycosiques et parasitaires associées au VIH » – Laboratoire de Parasitologie et Mycologie Médicale, UFR Pharmacie, Montpellier Cedex 5, France)
Remerciements à Donika Krasteva (Laboratoire de Parasitologie et Mycologie Médicale, UFR Pharmacie, Montpellier) pour les photographies.









